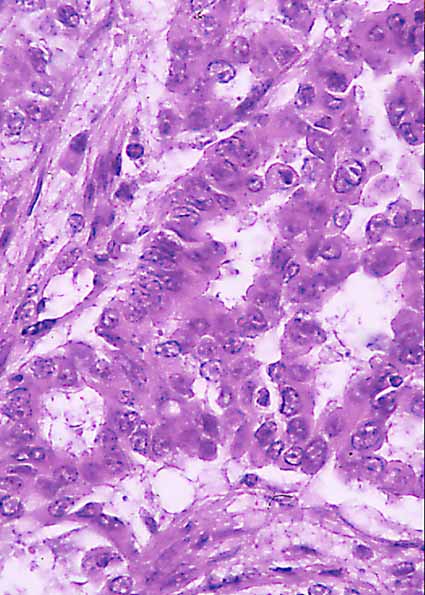
fig. 3

Půster
Nļ 031
Půster |
Gůmez Jimťnez, J; Cruz Cruz, MD; Martinez Torres,JL; Nogales Fernandez,F; Carvia Ponsaillť, RE; Zuluaga Gůmez,A
 |
| Figura 2.- Adenocarcinoma (H&E X 40): PequeŮo islote tumoral en el centro y tķbulos seminŪferos normales alrededor. |
|
| Figura 3.- Adenocarcinoma (H&E X 800): Cťlulas neoplŠsicas con tendencia a formar glŠndulas. Los nucleos muestran signos de atipicidad, nucleolo prominente. |
 |
| Figura 4.- Carcinoma escamoso (H&E X 40): Zona tumoral de hŠbito epitelial que se dispone en nidos.Tķbulos seminŪferos no afectados. |
 |
| Figura 5.- Carcinoma escamoso (H&E X 800): Cťlulas neoplŠsicas con marcado pleomorfismo nuclear y figuras de mitosis atŪpica. |